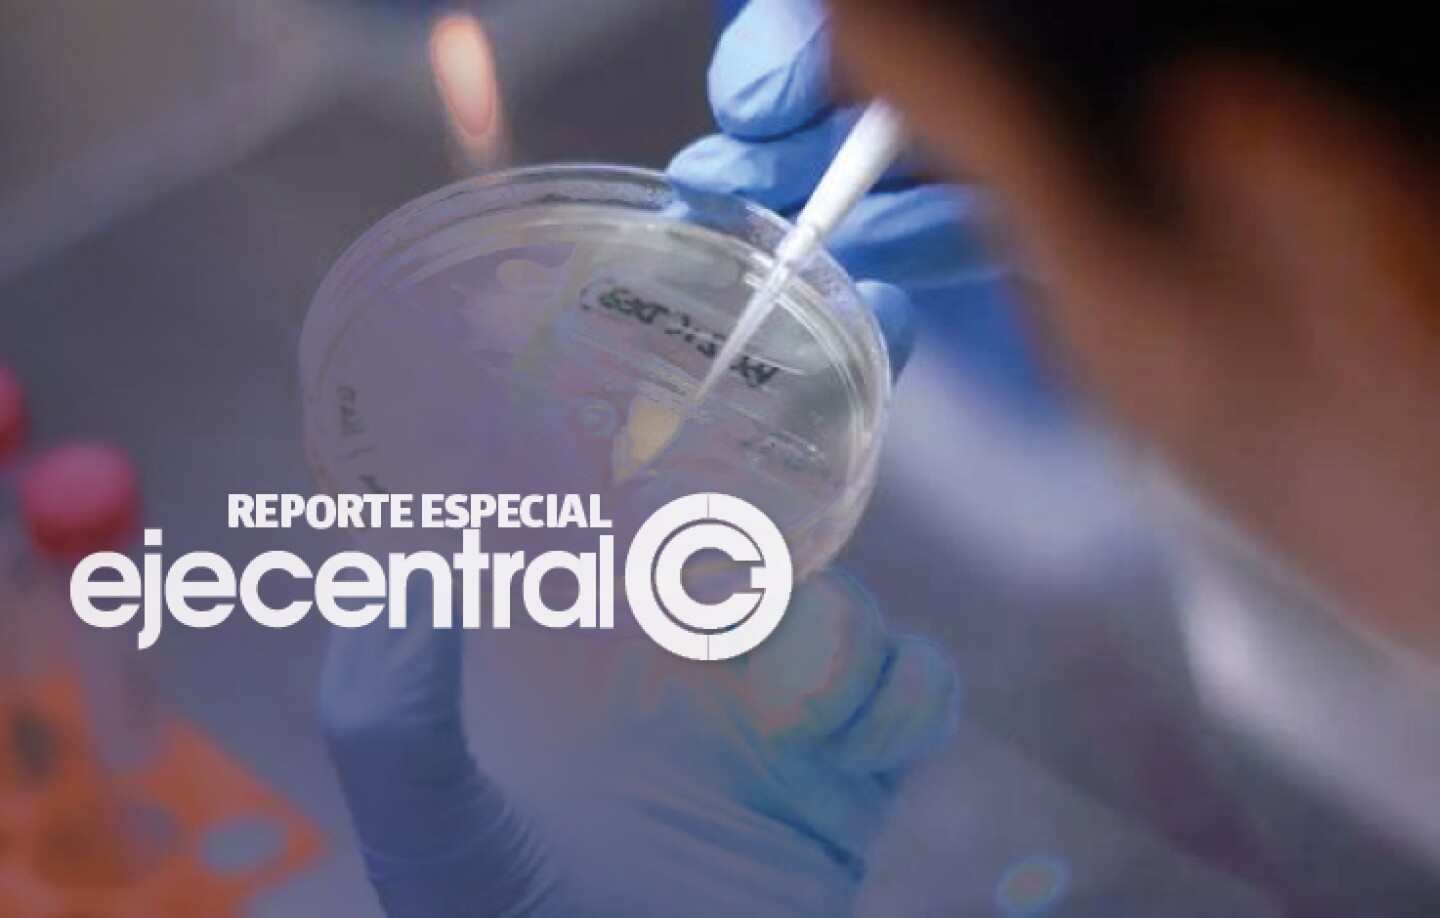

Delta obliga a regresar al uso de cubrebocas
Datos en diversos países refuerzan la idea de mantener estas medidas en todos los espacios públicos sin importar el estado de inmunización, alerta la OMS
Los nuevos brotes de contagios por Covid-19 asociados a la variante Delta, incluso entre quienes están completamente vacunadas, han encendido la alerta de la Organización Mundial de la Salud (OMS) que ha insistido en regresar al uso de mascarillas de manera universal en todos los espacios públicos sin importar el estado de inmunización de las personas.
Datos de diversos países refuerzan la idea de mantener estas medidas no farmacéuticas, especialmente ante la importante pérdida de efectividad que provoca Delta en las primeras dosis. Un nuevo estudio realizado en Estados Unidos muestra que la protección de una sola inyección de Pfizer pasó de 51% con los linajes anteriores a sólo 34% contra esta última variante.
Otros estudios muestran que Delta resta efectividad incluso con el esquema completo de Pfizer, pero esta es mínima en comparación a la caída que se reporta con una sola dosis de esta fórmula. Los investigadores encontraron que la efectividad contra la enfermedad sintomática entre personas totalmente vacunadas pasó de 93 a 88% con esta variante, lo que aún representa una proyección amplia.
Mutación mortal. La efectividad de Pfizer cae drásticamente ante la variante Delta, por lo que debe mantenerse la prevención.
Pero estos datos deben ser tomados con precaución ya que se obtuvieron antes de que Delta fuera la variante dominante en la mayoría de los países. Por ejemplo, un informe preliminar del Ministerio de Salud de Israel, en donde el 61.7% de la población ha recibido un esquema completo, muestra que la efectividad de las vacunas de Pfizer para prevenir la enfermedad sintomática cayó 33 puntos porcentuales desde que este linaje se impusiera a otros.
Estos nuevos estudios, así como las recomendaciones de organismos y autoridades de salud internacionales, deberían servir de guía para adecuar las medidas de protección en los países que aún no experimentan un crecimiento descontrolado de Delta, o cuyas tasas de vacunación están lejanas a la meta del 70% de cobertura.
Las recomendaciones de la OMS están enfocadas a proteger a las poblaciones más vulnerables, entre las que se cuentan enfermos que no pueden recibir la vacuna, o los niños menores de 12 años que aún no son elegibles para estas dosis.
Queda prohibida la reproducción total o parcial del contenido de esta publicación periódica, por cualquier medio o procedimiento, sin ello contar con la autorización previa, expresa y por escrito de ESTRICTAMENTE DIGITAL S.C.; toda forma de reproducción no autorizada será perseguida con lo establecido en la Ley Federal de Derecho de Autor. Derechos Reservados ©️, Estrictamente Digital S.C., 2021




